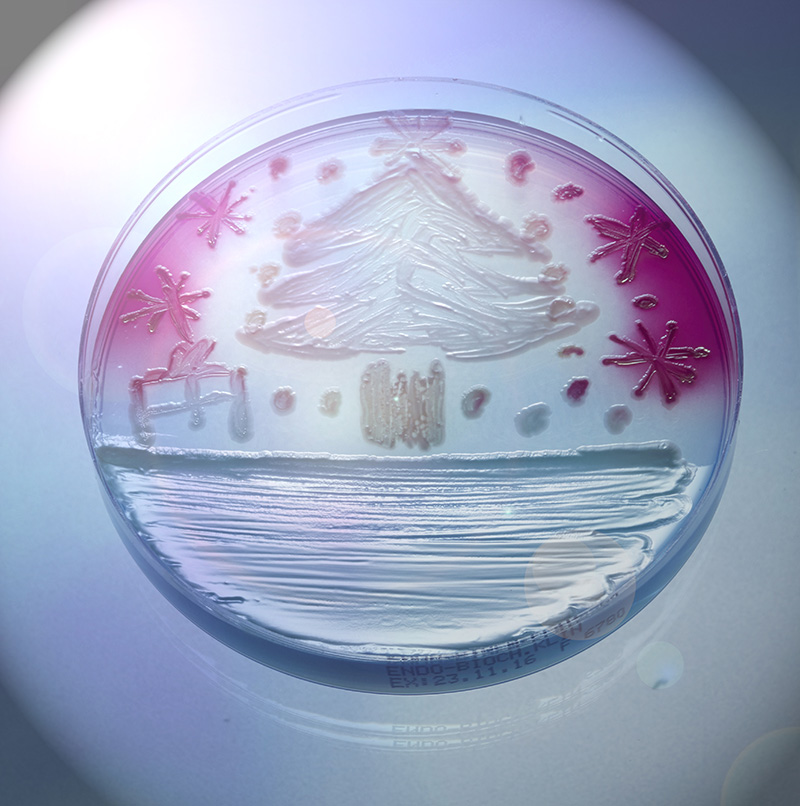

-
Naše zařízení
- Kliniky
-
Mamocentra
EUC Mamocentrum Bílina EUC Mamocentrum Brno EUC Mamocentrum Česká Lípa EUC Mamocentrum České Budějovice EUC Mamocentrum Kladno EUC Mamocentrum Liberec
-
Lékárny
EUC Lékárna České Budějovice EUC Lékárna Chrást EUC Lékárna Frýdlant EUC Lékárna Hradec Králové EUC Lékárna Hradec Králové - za Alessandrií EUC Lékárna Kladno EUC Lékárna Liberec - Klášterní EUC Lékárna Liberec - Pražská EUC Lékárna Olomouc EUC Lékárna Ostrava EUC Lékárna Pardubice EUC Lékárna Pardubice - Vektor EUC Lékárna PlzeňEUC Lékárna Praha - Kartouzská EUC Lékárna Praha - Majerského EUC Lékárna Praha - Opatovská EUC Lékárna Praha - Plaňanská EUC Lékárna Praha - Počernická EUC Lékárna Praha - Šustova EUC Lékárna Přelouč EUC Lékárna Slaný EUC Lékárna Zlín EUC Lékárna Ústí nad Labem EUC Lékárna Praha - Florenc EUC Lékárna Praha - Štúrova EUC Lékárna Liberec – Jizerská
-
Laboratoře a odběrová místa
EUC Laboratoře - hlavní stránka Koupit test v e-shopu
Odběrové místo Bílina Odběrové místo Brandýs nad Labem Odběrové místo České Budějovice Odběrové místo Dobřany Odběrové místo Hradec Králové Odběrové místo Kladno Odběrové místo Kolín Odběrové místo Králův Dvůr Odběrové místo Litvínov Odběrové místo LounyOdběrové místo Ostrava Odběrové místo PoděbradyOdběrová místa PrahaOdběrové místo Přelouč Odběrové místo Příbram Odběrové místo Říčany Odběrové místo Slaný Odběrové místo Týn nad Vltavou Odběrové místo Ústí nad LabemOdběrové místo Praha 1, Senovážné náměstíOdběrové místo Praha 2, Na SlupiOdběrové místo Praha 5, KartouzskáOdběrové místo Praha 6, BechyňovaOdběrové místo Praha 6, KamýckáOdběrové místo Praha 7, Fr. KřížkaOdběrové místo Praha 8, ZenklovaOdběrové místo Praha 10, PlaňanskáOdběrové místo Praha 11, OpatovskáOdběrové místo Praha 11, Šustova - Zobrazit všechna zařízení
- Lékaři a ordinace
- Obory léčby
- Kontakty
- Kariéra
-
Pro profesionály
Pro lékařeLaboratorní služby Prostory k pronájmu Odkup praxíPro zaměstnavatelePracovnělékařské služby Prémiová péče EUC PlusO skupině EUCInformace pro investory Výbor pro audit O nás
- E-shop
- Rezervovat léky
- EN
Upozornění: V případě respiračního onemocnění, prosíme o použití roušky v prostorách klinik. Chráníte tím sebe i ostatní. Děkujeme!
Zimní krása v EUC Laboratořích
18. ledna 2017 Pro média

Zima je v plném proudu nejen venku, ale také v EUC Laboratořích. Podívejte se na nádherné fotky zimních motivů, které „vypěstovali“ v Petriho miskách odborníci z našich laboratoří. Věřte, nevěřte. I tak neromantické prostředí, jako je diagnostická laboratoř, může mít nepřehlédnutelnou poetiku!
Podívejte se na drobné umělecké výtvory, které vytvořil v EUC Laboratořích tým MUDr. Kataríny Kučmašové. Vločky vznikly z houby rodu Aspergillus flavus a přesto, že se jedná o plíseň, která může být lidskému zdraví škodlivá, to co vzniklo v Petriho miskách, má svůj nesporný půvab.
Související články
Více článkůAlergie umí být i smrtící. Odhalit ji lze už ze dvou kapek krve
V České republice žije přes 2,5 milionu alergiků.[1] Odhaduje se však, že reálné číslo je mnohem vyšší – řada lidí totiž nemá alergii diagnostikovanou, nebo se u nich onemocnění ještě neprojevilo naplno. S určitým projevem alergie se podle statistik setkalo 9 z 10 Čechů.[2] Velmi běžná je například reakce na „zvířecí srst“, a to i u lidí, kteří čtyřnohého mazlíčka vlastní několik let. Během jarních měsíců zase mnohé trápí i alergie na pyl. Diagnostika tohoto onemocnění přitom může být velmi jednoduchá – například EUC Laboratoře disponují unikátním přístrojem který umí ze dvou kapek krve otestovat najednou až 295 různých alergenů.
více
Zdravotnická skupina EUC loni zvýšila obrat na 5,4 miliardy Kč. Do tří let plánuje investovat do rozvoje 2,5 miliardy korun
Největší tuzemský provozovatel ambulantní péče, zdravotnická skupina EUC, loni meziročně zvýšila obrat o 12 % na více než 5,4 miliard Kč. Skupina provedla celkem 3,7 milionu ambulantních vyšetření, což je meziročně o 6 % více, a zvýšila počet operací o 17 % na 7 tisíc. Rostla také v oblasti prémiové péče pod značkou Canadian Medical. Loni na podzim do skupiny přibyla akvizicí Domácí péče Včelka, jeden z největších poskytovatelů domácí zdravotní péče v ČR. Letos skupina EUC svou pozici lídra v oblasti těchto služeb dále posílila a koupila společnost Advantis Medical s.r.o. Během příštích tří let plánuje investovat 2,5 miliardy korun do nových zařízení, digitalizace a umělé inteligence.
více
Jak vybavit lékárničku na cesty
Lékárnička by měla patřit k nedílné výbavě každého cestovatele. Co všechno si s sebou sbalit na cesty? Nikdy by neměly chybět dlouhodobě pravidelně užívané léky a přípravky k léčbě většiny běžných zdravotních obtíží, jako je bolest a teplota, kašel, nachlazení, průjem či zácpa, alergie.
více
Staráte se správně o svá prsa? Jak na to ve 20, 30 a 40 letech
Ženská prsa se v průběhu let přirozeně mění. Nejde však jen o vzhled – ženy by si měly všímat především toho, zda jsou zdravá. S přibývajícími lety se totiž zvyšuje riziko vzniku rakoviny prsu. Od 20 let věku se proto doporučuje začít s pravidelným samovyšetřením, které by kolem třicítky již každá žena měla mít v malíčku. Na přelomu čtyřicítky přichází na řadu mamografické vyšetření, které je od 45 let věku hrazené ze zdravotního pojištění. Bezpečné je i pro ženy se silikonovými implantáty.
více